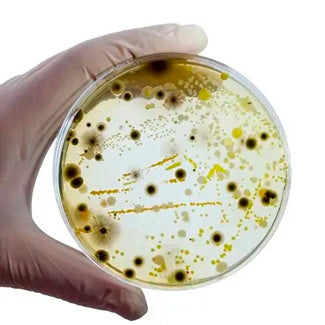

Wasserfilter im Test 2025 - Welcher ist der beste für Zuhause?
Auf der Suche nach dem besten Wasserfilter ist ein Wasserfilter Test und Vergleich eine wichtige Entscheidungshilfe, um die richtige Wahl zu treffen. Augenscheinliche Abhilfe bieten Webseiten namhafter Zeitungen und Magazine (ja sogar Computer-Fachzeitschriften). Alle haben Wasserfilter getestet und behaupten den besten Filter zu kennen, doch konzentrieren sich diese nur auf gezielte Produkte und betrachten nicht das ganze Angebot.
So werden durchweg fast nur Tischkannenfilter "getestet" und thematisiert. Das halten wir für sehr problematisch, denn gerade dieser Produkttyp kann aufgrund massiver Nachteile gar kein guter Wasserfilter sein! Welche Aspekte wirklich wichtig sind und worauf Sie achten sollten, erfahren Sie im folgenden Text.
Beste Wasserfilter Test bei Stiftung Warentest und ÖKO-Test
Obwohl Stiftung Warentest verschiedene Marken von Wasserfiltern getestet und entsprechend einen Testsieger gekürt hat, sind nur Tischkannenfilter im Test berücksichtigt worden. Hochwertige Wasserfilter wurden gar nicht bedacht, von daher sprechen wir auch von einer falschen Pauschalisierung von Wasserfilter. Dies ist den meisten Menschen überhaupt nicht bewusst und vermittelt den Eindruck, dass es nur Wasserfilter in dieser Form gibt, aber das stimmt nicht.
Bevor sie nun also Wasserfilter Testberichte zu der technisch einfachen aber limitierten Gattung der Tischwasserfilter lesen, macht es Sinn sich einmal die unterschiedlichen Filtersysteme und Produkte im Vergleich anzuschauen. Denn je nach Anwendungszweck besitzt jedes System unterschiedliche Stärken und Schwächen.
Welcher Wasserfilter ist der beste?
Wenn Sie genau wissen was Sie wollen, dann geht es wohl nur noch darum Preise zu vergleichen. Aber vor der Entscheidung für ein bestimmtes Filtersystem und in einem weiteren Schritt für einen Anbieter macht es Sinn zu klären, was Ihre Beweggründe zur Anschaffung sind.
Die gängigsten sind folgende:
- Leitungswasser enthält schädliche Verunreinigungen und schmeckt nicht
- Das Wasser ist zu hart und weniger Kalk ist gewünscht
- Die Schlepperei von Wasserkisten soll ein Ende haben und die Umwelt geschont werden
Gut zu Wissen:
Wissen Sie eigentlich was alles in unserem Leitungswasser so rumschwimmt und warum Wasserfilter sinnvoll sind?
Worauf achten beim Wasserfilter-Test
Unter Berücksichtigung der gewünschten Anschaffungsgründe macht es nun Sinn die gängigsten Wasserfilter am Markt und ihre Vor- und Nachteile zu betrachten. Denn um einfach nur reines Trinkwasser herzustellen gilt folgendes zu beachten:
- Die Qualität der Filtration weicht teilweise gewaltig voneinander ab und spielt somit eine große Rolle aus Kosten-Nutzen-Sicht.
- Je nach System gibt es wesentliche langfristige Aspekte (ökonomische durch Folgekosten oder qualitative durch eine Verschlechterung der Wasserqualität bei mangelhafter Wartung und Reinigung -> Stichwort: Verkeimung).
Zu den nachfolgend gängigsten Verfahren der Wasserfiltration gehören Tischfilter/Kannenfilter, Aktivkohle-Blockfilter, Osmosefilter, Dampfdestillation, Ionenaustauscher und Wasserionisierer.
Beste Wasserfilter: Unser Vergleich
Ein guter Wasserfilter Test sollte daher je nach Beweggrund und Anwendungszweck anhand unterschiedlicher Testkriterien wie Filtertechnik und -Leistung, Kosten und Folgekosten auch anhand von ökologischen und gesundheitlichen Gesichtspunkten betrachtet werden.
Die nachfolgende Darstellung zeigt Arten von Wasserfiltern und fokussiert sich auf die Frage, wie gut das jeweilige System zur Trinkwasseraufbereitung geeignet ist.
Typ | Kannenfilter | Wasserspender mit Filter | Aktivkohle-Blockfilter | Umkehrosmose | Dampfdestillation | Ionentauscher | Wasserionisierer |
---|---|---|---|---|---|---|---|
Bild | ![]() | ![]() | ![]() | ![]() | ![]() | ![]() | ![]() |
Leitungsgebunden? | Nein | Nein | Ja | Meistens | Nein | Modellabhängig | Ja |
Filtertechnik | Aktivkohlegranulat & Ionentausch | Aktivkohlegranulat & Ionentausch | Aktivkohle-Monoblock | Hyperfiltration | Destillation | Ionentausch | Elektrodialyse |
Schadstoffrückhaltung | sehr wenig | wenig | sehr gut | herausragend | sehr gut | wenig bis keine | wenig bis keine |
Vorteile | geringe Anschaffungskosten entnimmt Kalk und Chlor Mineralien bleiben im Wasser | meist optisch ansprechend entnimmt Chlor und reduziert Kalk Mineralien bleiben im Wasser | Hohe Schadstoffrückhaltung und Aufnahmekapazität Adsorption entnimmt auch Medikamentenrücktände zuverlässig Kein Zusatz von Silber Keimdurchbruch nicht möglich Mineralien bleiben im Wasser | fast vollständige Reinigung von Schadstoffen bzw. allen Inhaltsstoffen | hochgradig reines Wasser | Selektive Schadstoffentnahme durch Tausch | Erzeugt Basisches Wasser |
Nachteile | umständliches Nachfüllen von Wasser stark begrenzte Filterleistung von Schadstoffen Schadstoffdurchbruch möglich hohes Verkeimungsrisiko giftiges Silber als Desinfektionsmittel ggf. Weichmacher im Gehäuse in Relation zur Leistung hohe Folgekosten | umständliches Nachfüllen von Wasser stark begrenzte Filterleistung von Schadstoffen Schadstoffdurchbruch möglich hohes Verkeimungsrisiko ggf. giftiges Silber als Desinfektionsmittel in Relation zur Leistung hohe Folgekosten | gelöste Stoffe wie Kalk oder Nitrat bleiben im Wasser Filterwechsel alle 6 Monate | Wasserverschwendung Filtrat sauer, aggressiv und ohne Mineralien Nachträgliche Anreicherung mit Mineralien Biophysikalisch totes Wasser Sehr wartungs- und pflegeintensiv Problem der retrograden Verkeimung | umständliches Nachfüllen von Wasser nur Reste von Benzol und Chlor verbleiben sehr hoher Stromverbrauch großer Zeitaufwand (mehrere Std. pro Liter) großer Reinigungsaufwand nach jeder Anwendung Filtrat sauer, aggressiv und ohne Mineralien | Kein Wasserfilter, Menge an Inhaltsstoffen bleibt unverändert Erschöpfung des Tauscherharzes schwer ermittelbar und plötzlich Teure Anschaffung insb. Entkalkungsanlagen Je nach Anwendung Ausgangswasser kein Trinkwasser mehr | Kein Wasserfilter im eigentlichen Sinne - Reduktion von Schadstoffen steht nicht im Vordergrund Wissenschaftlicher Nutzen umstritten Sehr teure Anschaffungskosten Anfällig für retrograde Verkeimung |
Kosten / Folgekosten | Anschaffung: 20-60 EUR / Kartuschen: 4-20 EUR (alle 2-4 Wochen) | Anschaffung: 150-400 EUR / Filtereinsätze: ca. 40 EUR (alle 2 Monate) | Anschaffung: 120-300 EUR / Filtereinsätze: 40-100 EUR (alle 6 Monate) | Anschaffung: 200-5.000 EUR / Vorfilter, Sedimentfilter, Membran (alle 3 bis 24 Monate) | Anschaffung: 250-2.000 EUR / Strom: 1 KWh pro Liter plus Desinfektionsmittel | Anschaffung: 500-1.500 EUR / Spezialharz 0,2-0,4 EUR pro Tag | Anschaffung: 500-3.500 EUR / Stromverbrauch & Desinfektionsmittel ggf. Filtereinsätze |
FAZIT | wenig geeignet | wenig geeignet | sehr gut geeignet | gut geeignet | bedingt geeignet | ungeeignet | ungeeignet |
Zum Produkt | -> Unsere Filter entdecken |
Tischwasserfilter im Test

herkömmlicher Tischkannenfilter
Tischwasserfilter sind die wohl bekannteste Form von Wasserfilter in Deutschland. Neben anderen hat sich Hersteller Brita mit ihnen einen Namen gemacht. Ihre einfache Handhabung machen sie sehr beliebt, ihre Bezeichnung als Wasserfilter könnte man allerdings als irreführend bezeichnen. Insbesondere das verwendete lose Aktivkohlegranulat weißt große Schwächen auf. Diverse weitere Mängel machen Tischkannenfilter wenig empfehlenswert, obwohl viele Wasserfilter Tests anderes vermitteln wollen.
Verwendung
Tisch- und Kannenfilter dienen in erster Linie der Verbesserung des Leitungswassers im Hinblick auf Geschmack und Aussehen. Hiermit sind insbesondere die bei der Zubereitung von Heißgetränken entstehenden Flecken und Schlieren auf der Getränkeoberfläche, aufgrund von zu hartem kalkhaltigem Wasser.
Diese sehen unappetitliche aus und beeinträchtigen zudem Geschmack und Aroma. Tischwasserfilter sollen hier Abhilfe schaffen und das Wasser von den unerwünschten Eigenschaften befreien, insbesondere indem sie Kalk entfernen bzw. das Wasser weicher machen. Insbesondere ein Grund für Liebhaber von Kaffee und Tee.
Filtertechnik
In der Kanne befindet sich ein Trichter samt Filterkartusche. Das oben eingefüllte Wasser durchläuft den Filter und wird im Vorratsbehälter aufgefangen. In der Kartusche selbst werden mittels granuliertem Kunststoffharz und losem Aktivkohlegranulat zwei Filtertechniken kombiniert.
Das Harz ersetzt mittels Ionentausch im Wasser vorhandene Anionen/Kationen durch andere Ionen. Somit lassen sich zum Beispiel die für die Kalkbildung verantwortlichen Calcium und Magnesium reduzieren, sodass das Wasser weicher wird. Allerdings nur bis das Tauscherharz erschöpft ist.
In Kombination hierzu wird zusätzlich lose geschüttetes Aktivkohlegranulat benutzt, welches Geruchs- und geschmacksstörende Stoffe wie Chlor und organische Verbindungen entnehmen soll.
Vor- und Nachteile
Die Anschaffungskosten für Tischkannenfilter sind sehr gering und eine Installation an die Wasserleitung ist nicht notwendig. Inhaltsstoffe wie Kalk und Chlor werden wirksam entfernt, vereinzelt sogar Schwermetalle wie Blei oder Kupfer.
Der größte Nachteil ist die grundsätzlich sehr begrenzte Filterleistung. Kaum ein Anbieter weist überhaupt aus, was eigentlich gefiltert wird. Die klassischen Verunreinigungen wie Pestizide, Bakterien und Keime, Schwermetalle, Hormone oder Medikamente werden überhaupt nicht gefiltert.
Der zweite große Nachteil liegt im sehr hohen Verkeimungsrisiko. Diese offenen Systeme sind fortwährend der Luft und schwankenden bis hin zu warmen Temperaturen (z.B. durch Sonneneinstrahlung) ausgesetzt. D.h. der Wasserfilter filtert nicht nur wenig und verkeimt mit hoher Wahrscheinlichkeit.
Verkeimung von Wasserfilter
Dieses Umfeld bietet optimale Bedingungen für im Filtermaterial gesammelte Keime und Bakterien, um sich zu vermehren und im gefilterten Wasser anzureichern. Viele Hersteller sind der Überzeugung, dass diese Keime nicht gesundheitsgefährdend sind. Nichtsdestotrotz werden viele Filterkartuschen mit dem Schwermetall Silber als Desinfektionsmittel versehen, um die Keimbildung einzudämmen.
Die Kartuschen geben allerdings geringe Silbermengen in das gefilterte Wasser ab, was laut Umweltexperten sehr fragwürdig ist. Sie sind der Meinung, dass das Schwermetall Silber im Trinkwasser nichts zu suchen hat. Gesundheitliche Langzeitschäden können somit nicht ausgeschlossen werden.
Bei nicht sachgemäßer Handhabung in Punkt Hygiene und nicht Beachtung der regelmäßigen Wartungsintervalle, kann sich die Trinkwasserqualität drastisch verschlechtern. Das lose Filtermaterial der Tischkannenfilter ist ab einem bestimmten Punkt gesättigt und kann somit keine neuen Schadstoffe mehr adsorbieren.
In der Folge kann es zum Durchbruch kommen und die aufgenommenen Stoffe werden unkontrolliert wieder ins Wasser abzugeben. Dies widerspricht jedwedem ursprünglichen Anwendungsziel.
Weitere Nachteile sind die Filtergehäuse aus mitunter fragwürdigem Plastik, was Weichmacher ermöglicht an das gefilterte Wasser abgegeben zu werden und besonders hohe (versteckte) Folgekosten in den Verbrauchsmaterialien zum vergleichsweise geringen Anschaffungspreis.
Die Filterkartuschen sind schnell erschöpft und müssen entsprechend oft (ca. alle 4 Wochen) ausgetauscht werden.
Wasserspender mit Filter im Test

Wasserfilterung mittels Schwerkraft
Diese turmförmigen Wasserspender mit integriertem Wasserfilter nutzen ebenfalls "nur" die Schwerkraft um das in den Tank gefüllte Wasser über mehrere vorwiegend lose Filterebenen sickern zu lassen. Sobald das Wasser durchgelaufen ist kann dieses über einen kleinen Zapfhahn bezogen werden.
Verwendung
Wie der Name schon sagt handelt es sich um Wasserspender die aufgrund der Filterung eine Verbesserung des Leitungswassers im Hinblick auf Geschmack und Aussehen erzielen sollen. Die meisten Modelle sind relativ groß und nicht leitungsgebunden oder gekühlt. Wasser zur Aufbereitung muss regelmäßig in den Wassertank nachgefüllt werden was meistens eine Platzierung nahe der Küchenspüle zur Folge hat.
Filtertechnik
Neben Aktivkohlegranult, Ionentauscherharz kommen auch Fliecemembranen oder Mineralkeramiken zum Einsatz. Aufgrund des verwendeten Tauscherharzes wird auch der Kalkgehalt des Wasser reduziert.
Vor- und Nachteile
Meist sind diese Modelle optisch sehr ansprechend und gerade für kleine Unternehmen auch ideal um eine Nachfüllstation für gefiltertes Trinkwasser anbieten zu können.
Laut Hersteller werden Inhaltsstoffe wie Kalk und Chlor wirksam herausgefiltert, vereinzelt sogar Schwermetalle wie Blei und Kupfer.
Trotz des wesentlich höheren Preises unterliegen sie ähnlichen Nachteilen wie Kannenfilter. Das Wasser umspült meist nur die losen Filterelemente und somit bleiben sie in ihrer Leistungsfähigkeit stark eingeschränkt. D.h. sie sind nicht in der Lage die meisten gängigen Verunreinigungen aus dem Wasser zu filtern.
Die Wasserspender mit Filter sind ungekühlt und dadurch ebenfalls schwankenden bis hin zu warmen Temperaturen ausgesetzt. Die Filterelemente sind durchweg feucht und bieten somit ebenfalls ideale Voraussetzungen für Verkeimung.
Um diesem Problem entgegenzuwirken wird möglicherweise das Schwermetall Silber als Desinfektionsmittel zugegeben. Der Bauform geschuldet ist auch von der Möglichkeit eines Schadstoffdurchbruchs auszugehen.
Die Filterkartuschen sind ebenfalls vergleichsweise schnell erschöpft und müssen entsprechend oft ausgetauscht werden. Sie können daher nur relativ wenige Liter Wasser filtern.
Vergleichen Sie unbedingt die Herstellerangaben im Detail. Kalkfilter-Pads müssen mitunter alle 2 Wochen und die Kauptkartusche alle 2 Monate getauscht werden. Neben dem erhöhten Aufwand sind diese laufenden Betriebskosten auch kein unwesentlicher Aspekt.
Aktivkohle-Blockfilter im Test

hochwertiger Aktivkohle-Wasserfilter
Aktivkohle gehört zu den meistverwendeten Formen in der Wasserfilterung, allerdings kommt es auf die entsprechende Herstellungsform an. Als Monoblockfilter werden nicht nur die Nachteile von Tischkannenfilter überwunden, da diese ausschließlich leitungsgebunden betrieben werden, sondern auch eine sehr überzeugende Filterleistung geschaffen. Ein Monoblockfilter reinigt das Wasser äußerst gründlich mittels Wasserdruck.
Verwendung
Aktivkohleblockfilter werden als Filtereinsätze für Auf- oder als Untertischfiltersysteme angeboten und direkt an den Wasserkreislauf angeschlossen. Idealerweise dort wo das Trinkwasser entnommen werden soll, meist in der Küche. Das Leistungsspektrum ist wesentlich größer als bei Tischkannen- oder Aktivkohle-Granulatfilter und ermöglicht somit die Herstellung von qualitativ hochwertigem Trinkwasser.
Filtertechnik
Das Aktivkohle auch sehr gut zur Wasserreinigung geeignet ist, zeigen moderne Aktivkohle-Blockfilter. Hierbei wird kein lose geschüttetes Aktivkohlegranulat zur Filterung verwendet, sondern unter hohen Temperaturen in Blockform gebackene verbundene Aktivkohle (Prozess der Sinterung).
Dies führt zu einer komplett anderen Form der Filterung, da das Wasser nicht nur außen um ein Aktivkohlegranulat gespült wird, sondern durch ein festes Filterelement den Aktivkohle-Monoblock unter Druck gelenkt wird.
Dieses extrem verdichtete Filtermedium verfügt über unzählige feiner Poren und Kanäle im Inneren, vergleichbar mit einem Sieb, und lässt das Wasser dabei mit einer riesigen Oberflächenstruktur zur Reinigung in Kontakt kommen.

Folgendes Vergleichsbild zeigt welche Aktivkohleform in welcher Filtertyp oftmals zur Anwendung kommt:

A
Klassiche Kannenfilter enthalten loses Aktivkohlegranulat (schwarze Partikel) meistens vermengt mit einem Ionentauscherharz (weisse Partikel).

B
Loses Aktivkohlegranulat(A) oder sehrkleine Aktivkohleblöcke(B) werden auch häufig in Gehäuseformen verwendet die direkt am Wasserhahn befestigt werden können.

C
Gesinterte Aktivkohle-Monoblockfilter im 10-Zoll Format komplett ohne chemische Zusätze als Auftischfilter oder

als Einbau-Wasserfiler zur Montage unter der Spüle. Hierfür stehen drei unterschiedliche Einbauversionen zur Verfügung.
Vor- und Nachteile (bezogen auf gesinterte Aktivkohle-Blockfilter in C)
Qualitativ hochwertige Aktivkohlefilter verfügen über eine äußerst hohe Aufnahmekapazität und können somit viele Schwebstoffe und partikuläre Belastungen aus dem Wasser entfernen. Hierzu gehören neben Rostpartikeln, Sand und Asbestfasern auch Schwermetalle, Medikamentenrückstände, Bakterien, Pestizide, Parasiten, Chlor und weitere organische Verbindungen.

Querschnitt ABF Primus EM.
Ihre besondere Eigenschaft der Adsorption (Anziehung) entnimmt sogar schwer abbaubare Halogen-Kohlenwasserstoffe und unpolare Pestizide. Diese Anziehungskräfte der Kohlenstoff-Oberfläche zieht Schmutzteilchen und Partikel an und hält diese dauerhaft fest bis die Aktivkohle gesättigt bzw. vollständig beladen ist.
Hierbei kann es aufgrund der Bauform nicht zu einem plötzlichen Durchbruch wie bei losem Granulat kommen. Der Wasserdurchfluss lässt allerdings merklich nach und erfordert einen Wechsel des Filtereinsatzes.
Auch benötigen Aktivkohle-Blockfilter kein Silber zur Wasserdesinfektion und belassen lebenswichtige und geschmacksbildende Mineralstoffe im Wasser. Der pH-Wert wird somit auch nicht verändert.
Gelöste Inhaltsstoffe werden nicht gefiltert, hierzu gehören neben Kalk (Kalzium/Magnesium) auch Nitrat, Nitrit und Ammonium. Auch gelöste Schwermetalle und gelöstes Aluminium verbleiben im Wasser.
Ähnlich wie bei einem Schwamm kann der Aktivkohleblock nur eine bestimmte Menge an Schadstoffen aufnehmen. Daher sind Filterwechsel nach spätestens sechs Monaten notwendig.
Umkehrosmose-Wasserfilter im Test

Klassische Darstellung einer Umkehrosmoseanlage mit zusätzlichem Tank
Umkehrosmose bzw. die Hyperfiltration ist ein gängiges und anerkanntes synthetisches Verfahren zur hochgradigen Reinigung von Wasser. Neben der Aktivkohle-Blockfiltration ist es wohl der meistverkaufte Typus eines Wasserfilters am Markt. Auf den ersten Blick der beste Wasserfilter am Markt allerdings mit nicht zu verachtenden Nachteilen. Die Anschaffung sollte wohl überlegt sein.
Verwendung
Die Umkehrosmose wird weltweit sowohl in der industriellen Herstellung von Tafelwasser (z.B. Babywasser) und Prozesswasser (z.B. für Apotheken) sowie zur Aufbereitung von sehr salzigem Meerwasser eingesetzt.
Es stellt das feinste anwendbare Filtrationsverfahren überhaupt dar, denn das resultierende Osmosewasser enthält nur noch H2O-Moleküle sowie wenige kleine gelöste Ionen.
Daher hat diese Technik auch längst Einzug in die Privathaushalte genommen und wird in Form von Küchengeräten als Auf- und Untertischmodell angeboten. Die meisten Anlagen sind nicht für die Wasserversorgung des ganzen Hauses gedacht und müssen permanent ans Leitungswassernetz angeschlossen sein.
Filtertechnik
Die Umkehrosmose ist ein äußerst feines mechanisches Filtrationsverfahren (auch Hyper-Filtration genannt). Über künstlich erzeugten Druck wird Wasser durch eine halbdurchlässige Membran aus vernetztem Komsosit-Kunststoff gepresst, welche nur die Wassermoleküle durchlässt und alle anderen Inhaltsstoffe aufgrund ihrer Größe und dem Naturphänomen der Osmose zurückhält.
Die Membran als solche ist kein Sieb bzw. nicht porös, sondern kann lediglich in ihren Molekülzwischenräumen Wasser aufnehmen. Das auf der Ausgangsseite der Membran gesammelte Filtrat wird auch Permeat genannt und ist eine rein synthetische Flüssigkeit.
Zur reibungslosen Funktion müssen die auf der Eingangsseite aufgestauten Rückstände stetig abgeführt und frisches Rohwasser an die Membran geleitet werden.
Vor- und Nachteile
Die Umkehrosmose-Technik ermöglicht eine fast vollständige Reinigung des Trinkwassers von Schadstoffen. Praktisch alle bekannten ungelösten und gelösten Fremdstoffe können nahezu vollständig entnommen werden.
Auch Stoffe, die Aktivkohle nicht adsorbieren kann, wie die Kalkbildener Kalzium und Magnesium oder Nitrat und Nitrit. Der Anteil an gelösten Stoffen insgesamt wird um 85 bis über 99% reduziert.

Schaubild Umkehrosmose-Membranfilter
Umkehrosmoseanlagen verschwenden Wasser da besonders hohe Abwassermengen zum Betrieb benötigt werden. Pro hergestellten Liter Osmosewasser werden 3-10 Liter Leitungswasser benötigt. Der Menge an Abwasser hängt von Wasserdruck, Temperatur und Modell (mit oder ohne Vorratstank) ab.
Das erzeugte reine Wasser hat meist einen pH-Wert zwischen 4,5 und 5,5 und liegt somit im sauren Bereich. Neutrales alkalisches Wasser besitzt hingegen einen pH-Wert von 7,0 unser Blut sogar 7,4. Über die gesundheitlichen Konsequenzen von derartigem saurem Wasser wird viel diskutiert.
Verfechter der Umkehrosmose argumentieren, dass saures Wasser dem Körper hilft sich selbst zu entsäuern, die Gegentheorie besagt, dass derartiges Wasser eher sogar dem Körper lebenswichtige Mineralien entzieht, da es selbst ein starkes Bedürfnis zur Sättigung hat. Insbesondere die Langzeitaufnahme von demineralisiertem Wasser gilt als nicht empfehlenswert.
Mittlerweile sind viele Hersteller dazu übergegangen, das Osmosewasser im Nachgang mit Mineralstoffen wieder anzureichern, um dem Wasser seinen natürlichen höheren pH-Wert wiederzugeben. So wird auch der Geschmack des Wassers wiederhergestellt.
Der sehr komplexe und rein synthetische Herstellungsprozess zerstört zusätzlich die natürliche Sauerstoffmolekularstruktur des Wassers. Daher spricht man aus biophysikalischer Sicht auch von totem Wasser. Lebendiges Wasser hingegen besitzt eine harmonische und geordnete Struktur der Wassermoleküle und soll in der Lage sein die lebensspendenden Funktionen im menschlichen Organismus besser zu erfüllen.
Osmoseanlagen sind aufgrund ihrer technischen Komplexität besonders pflege- und wartungsintensiv. Mehrere Vor- und Nachfilter bedürfen des regelmäßigen Austauschs (2-6 Monate), sowie die künstliche Filtermembran selbst (alle 2-4 Jahre). Auch die Installation und der Austausch der Membran vom Laien nur schwer umzusetzen und bedarf der Hilfe eines Fachmanns.
Längere Stillstandszeiten oder zu geringer Wasserdruck gleichbedeutet mit keiner ausreichenden Spülung der Membran, können diese stark schädigen und zu Bakterienwachstum sogar durch die Membran hindurch führen.
Diese retrograde Verkeimung stellt ein gängiges Problem dar, so das entweder regelmäßige Desinfektionsintervalle durch Wasserstoffperoxid oder Chlor angeraten wird.
Manche Anlagen verfügen sogar zur Entkeimung über nachgelagerte UV-Bestrahlung, diese erhitzt das Wasser und verbraucht zusätzlich Strom. Theoretisch ist sogar eine Umwandlung der nicht gefilterten Nitratreste zu Nitrit möglich. Dieses gilt als krebserregend.
Dampfdestillation im Test

Beispiel Dampfdestilliergerät mit Auffangbehälter
Destilliertes oder demineralisiertes Wasser ist ideal für die Verwendung in Bügeleisen und der Autobatterie. In der Industrie und in Laboren sowie Apotheken ist es als Prozesswasser von Bedeutung.
Aufgrund seines hohen Reinheitsgrad wird das Prinzip von verschiedenen Herstellern auch zur Trinkwasseraufbereitung in Form von Dampfdestillationsgeräten für den Haushalt vertrieben. Diverse Nachteile machen dieses Verfahren allerdings weniger empfehlenswert.
Filtertechnik
Bei der Destillation (lat. destillare „herabtröpfeln“) handelt es sich um ein thermisches Trennverfahren, in welchem zunächst das Ausgangswasser unter Zufuhr von Energie zum Sieden gebracht wird. Es entsteht Wasserdampf, der im Gerät aufsteigt und durch anschließende Kühlung wieder zu flüssigem Wasser kondensiert und in einem Vorratsbehälter aufgefangen wird.
Vor- und Nachteile
Im Ergebnis erzeugt die Dampfdestillation ein hochgradig reines Wasser. Fast alle Inhaltsstoffe inklusive Schadstoffe und Mineralstoffe werden vollständig entfernt.
Der Reinheitsgrad ist sehr hoch, doch verbleiben leicht flüchtige Substanzen wie z.B. Benzole oder Chlor im Wasserdampf und somit im Kondensat. Das Gerät muss nach jeder Anwendung aufwendig gereinigt und desinfiziert werden, um die gesammelten Rückstände zu entfernen.
Ein weiterer wichtiger Nachteil, ist der besonders hohe Stromverbrauch von einer Kilowattstunde pro 1 Liter destilliertem Wasser. Hinzu kommt das pro gefiltertem Liter Wasser eine ganze Stunde vergeht, was wenig ergiebig ist.
Das erzeugte Wasser hat einen PH-Wert von 4 und ist damit stark sauer und reaktionsbedürftig (aggressiv). Für einen täglichen Gebrauch als Trinkwasser ist es zumindest äußerst fragwürdig, da destilliertes Wasser dem Organismus theoretisch wiederum Mineralien entzieht und nicht jedem gut bekommt.
Ionentauscher im Test (Entkalkungsanlagen)

Entkalkungsanlagen funktionieren mittels Ionentausch filtern aber keine Schadstoffe
Als Anschaffung zur Wasserreinigung ungeeignet. Entkalkungsanlagen machen zwar weicheres Wasser, filtern es aber nicht. Das Verfahren sollte auch privat nur in Kombination mit anderen Verfahren benutzt werden bzw. aufgrund der deutlichen Nachteile mit Bedacht ausgewählt werden.
Verwendung & Filtertechnik
Ionentauscher werden am häufigsten im Bereich der Härtereduktion (Kalk) oder Nitratentfernung verwendet. Das Verfahren als solches hat nichts mit Filtration zu tun, sondern tauscht mittels Spezialharz "Ionen" aus. Im Fall von Kalk Kalzium- und Magnesium- gegen Natrium-Ionen.
Die im Wasser befindliche Menge an Inhaltsstoffen verändert sich somit nicht, daher sind Ionentauscher als alleinige Filtrationsverfahren ungeeignet. Im privaten Gebrauch kommen Ionentauscher vorrangig in Tischkannenfiltern oder als größere Entkalkungsanlagen in Gebäuden zum Einsatz.
In der Industrie oder der dezentralen Wasseraufbereitung werden sie grundsätzlich immer mit anderen Wasseraufbereitungsformen kombiniert.
Vor- und Nachteile
Je nach verwendetem Spezialharz lassen sich gezielt einzelne Schadstoffe aus dem Wasser entnehmen bzw. tauschen.
Es handelt sich nicht um einen Wasserfilter, sondern nur um eine technische Methode gezielte Schadstoffe aus dem Wasser zu tauschen. Die breite Masse an Verunreinigungen bleibt somit im Wasser.

Illustration eines Ionentauschs zur Entkalkung
Der Zeitpunkt der Erschöpfung des Spezialharzes ist nur schwer bestimmbar, so dass eine sichere Entnahme kaum möglich ist. Bei Kalk mag das grundsätzlich kein Problem sein, bei Schwermetallen oder Nitrat schon eher.
Größere Anlagen zur Entkalkung sind in der Anschaffung teuer und bedürfen nicht nur ständiger, sondern auch aufwendiger Wartung und Regeneration bzw. Nachfüllung des Harzes. Auch entspricht das Ausgangswasser aufgrund von zu hoher Natriumwerte und zu geringem pH-Wert (zu sauer) oftmals nicht mal mehr den Anforderungen der Trinkwasserverordnung.
Insbesondere für Menschen mit hohem Blutdruck ist eine erhöhte Natriumaufnahme nicht zuträglich und unter Umständen sogar gefährlich.
Wasserionisierer im Test

Wasserionisierer legen den Fokus nicht auf die Schadstoffrückhaltung und sind somit als Wasserfilter wenig geeignet. Wer an Basisches Wasser als Gesundheitsbaustein glaubt, kann sich die sündhaft teure Anschaffung überlegen.
Verwendung & Filtertechnik
Wasserionisierer dienen der Herstellung von ionisiertem Wasser, bekannter unter dem Namen basisches Wasser. Mittels spezieller elektrolytischer Reaktion wird Leitungswasser in einen basischen Teil (Elektronenüberschuss) und einen sauren Teil (Elektronenmangel) getrennt.
Basisches "Aktivwasser" stellt eine synthetische Flüssigkeit zum Trinken dar, welche besondere gesundheitliche Wirkungen haben soll. Die Theorie dahinter basiert ähnlich dem Trend "Basische Ernährung" mittels basischem Wasser den durch Umwelteinflüsse und schlechte Ernährung versauerten Körper auszugleichen bzw. zu reinigen.
Filtertechnik
Ein Wasserionisierer wird direkt in den Wasserkreislauf eingebunden. Normalerweise wird das zu ionisierende Eingangswasser mittels Aktivkohle vorgefiltert. Gelöste Stoffe verbleiben somit im Wasser. Im Elektrodialyseprozess werden nun keine Ionen erzeugt, sondern die im Wasser befindlichen Ionen mittels Strom durch eine Trennmembran verschoben und in zwei Behälter aufgeteilt. In ein Anolyt (saures Oxidwasser) und ein Katholyt (Aktivwasser mit erhöhtem pH-Wert von 7-14). Im Endeffekt Wassermoleküle aufgespalten und wieder neu zusammensetzt. Mit einer Filterung von Schadstoffen und Verunreinigungen hat dies weniger zu tun.
Vor- und Nachteile
Wie die Basische Ernährung selbst gilt Basisches Wasser als gesundheitsfördernd. Eindeutige wissenschaftliche Belege gibt es hierzu allerdings nicht. Die Wirkung selbst kann bei jedem Menschen unterschiedlich sein. Auch vertragen manche Menschen basisches Wasser überhaupt nicht.
Neben den teilweise sehr hohen Anschaffungskosten handelt es sich eigentlich nicht um einen klassischen Wasserfilter zu Reinigung des Wassers, sondern vielmehr um eine künstliche Zerlegung auf Ebene von geladenen Teilchen.
Zwar enthalten manche Geräte vorgeschaltete Aktivkohlefilter, allerdings kommt es hierbei stark auf deren Qualität und Herstellungsform an (siehe Kannenfilter mit Aktivkohle-Granulat und gesinterte Aktivkohle-Blockfilter). Die Reduktion von Schadstoffen steht nicht im Vordergrund.
Weitere bekannte Nachteile ist die retrograde Verkeimung im inneren des Gehäuses bei nicht ausreichender Wartung und Pflege durch regelmäßige Desinfektion.
Outdoor Wasserfilter im Test
Wasserfilter im Vergleich gibt es auch gezielt für Outdoormodelle. Gute Outdoor Wasserfilter können an jedem Ort und jederzeit für keimfreies und sicheres Wasser sorgen. Neben chemischer Wasseraufbereitung mittels Tabletten gibt es Outdoorfilter auf Membranbasis die sicher Mikroorganismen, Parasiten und Viren filtern oder Kombinationsfilter mit Aktivkohle (wie z.B. Grayl Wasserfilter) die auch den Geruch und Geschmack des Wassers verbessern. Letzterer ist unser Favorit.
Zum Anfang
Fazit - Wasserfilter Testsieger
Unser Wasserfilter Vergleich zeigt, dass bei genauerer Betrachtung der gängigsten auf dem Markt verfügbaren Wasserfilter für den Privateinsatz, das wichtigste Kriterium folgendes ist: Ein guter Wasserfilter sollte unbedingt leitungsgebunden sein.
In Punkto Leistungsfähigkeit kristallisieren sich deutlich gesinterte Aktivkohle-Blockfilter und Umkehrosmose-Filtersysteme heraus. Da beide über eine sehr gute Schadstoffreduktion verfügen bleibt es eine Philosophiefrage welcher Wasserfilter ihr persönlicher Testsieger ist:
Bevorzugen Sie Wasser in seiner natürlichen Zusammensetzung mit geschmacksprägenden und lebensnotwendigen Mineralien oder ist Ihnen eine perfekte Schadstoffreduktion durch synthetisch komplett zersetztes und wieder aufbereitetes Wasser lieber.
Unser Testsieger
Ob nun der beste Filter oder Testsieger, mit unseren Aktivkohle Wasserfilter haben Sie eine hervorragende Option mit folgenden Benefits zur Auswahl:
- Leitungsgebundene hochwertige Gehäuse - d.h. immer frisch gefiltertes Trinkwasser aus der eigenen Leitung
- Flexible und komfortable Anschlussmöglichkeiten auf- und unter der Spüle.
- Seit mehr als 20 Jahre bewährte und TÜV-zertifizierte Filtertechnologie
- Alle gängigen Verunreinigungen werden entnommen, wichtige Spurenelemente und Mineralstoffe verbleiben im Wasser
- Sehr leistungsfähige Filterelemente Made in Germany - nur alle sechs Monate zu wechseln
und das zu einem hervorragenden Preis-Leistungs-Verhältnis.
Beste Wasserfilter für Zuhause
Wählen Sie zwischen einem Auftisch Trinkwasserfilter direkt am Wasserhahn. Per Umschalthebel wechseln Sie zwischen gefiltertem und ungefiltertem Leitungswasser oder einem komfortablen Einbaufilter unter der Spüle montiert.
Tipps für den besten Wasserfilter
Leider stempeln Verbraucherzentralen und renommierte Test-Institute Wasserfilter oftmals pauschal als nutzlos ab. Das hängt zum einen an den fälschlicherweise nur betrachteten Kannenfiltern und zum anderen an der Annahme, dass das deutsche Leitungswasser im weltweiten Vergleich von sehr guter Qualität, ist und somit keine Wasserfilter im privaten Bereich nötig sind. Aber genauso gut lassen sich sehr gute Argumente für einen Wasserfilter anbringen.
Wer einen Wasserfilter kaufen möchte, sollte auch darauf achten nicht blind auf fragwürdige Anbieter zu setzen, die für den Vertrieb ausschließlich Multi-Level-Marketing (Schneeballsysteme) nutzen. Hierbei erhalten Vertriebsmitarbeiter sehr hohe Verkaufsprovisionen und haben somit großen Anreiz ihnen das Blaue vom Himmel zu erzählen. Meist wird bei Hausbesuchen ihr Leitungswasser mittels fragwürdiger Messmethoden (z.B. einem TDS-Messgerät zur Bestimmung des Leitwerts) getestet. Natürlich soll das Ergebnis negativ überraschen, um den heiligen Gral (das eigene exklusive Produkt) für teures Geld zu verkaufen. In den meisten Fällen handelt es sich hierbei um Umkehrosmose Wasserfilter.
Bevor Sie also einen Kaufvertrag abschließen lassen Sie sich nicht unter Druck setzen und informieren sich in Ruhe über den jeweiligen Anbieter und erstellen ihre eigene Wasserfilter-Bestenliste. Frage-Antwort-Foren und kritische Berichterstattungen bieten gute Anhaltspunkte. Die Anbieter-Webseiten enthalten leider oftmals wenig transparente Produktinformationen und nutzen gerne prominente Gesichter als Werbebotschafter. Alles um den hohen Kaufpreis zu rechtfertigen.
Auch zeigen die meisten Wasserfilter Tests bzw. Vergleiche nur eine stark eingeschränkte Auswahl an Produkten und Filtertechnologien. Kaufen Sie nicht einfach irgendeinen Wasserfilter, sondern versuchen Sie die dahinterliegende Technologie und ihre Vor- und Nachteile zu verstehen.
In größeren Städten lassen sich auch unterschiedliche Modelle von Wasserfilter testen und so im eigenen Praxistest der persönliche Wasserfilter Testsieger küren.
Quellen & Weiterführende Informationen
- Stiftung Warentest (2022) - Wasserfilter Test
- ÖKO-Test (2022) - "Wie sinnvoll sind Wasserfilter"
- Verbraucherzentrale (2022) - "Brauche ich einen Wasserfilter?"
- ÖKO-Test (2014) - Schadstoffen im Wasser in Großstädten
- Stiftung Warentest (2019) - Trinkwasser im Test
- Alvito GmbH (2023) - Filtervermögen Aktivkohle
- Carbonit (2007) - Umkehrosmose & Co. - Alternative Filtrationsverfahren unter der Lupe